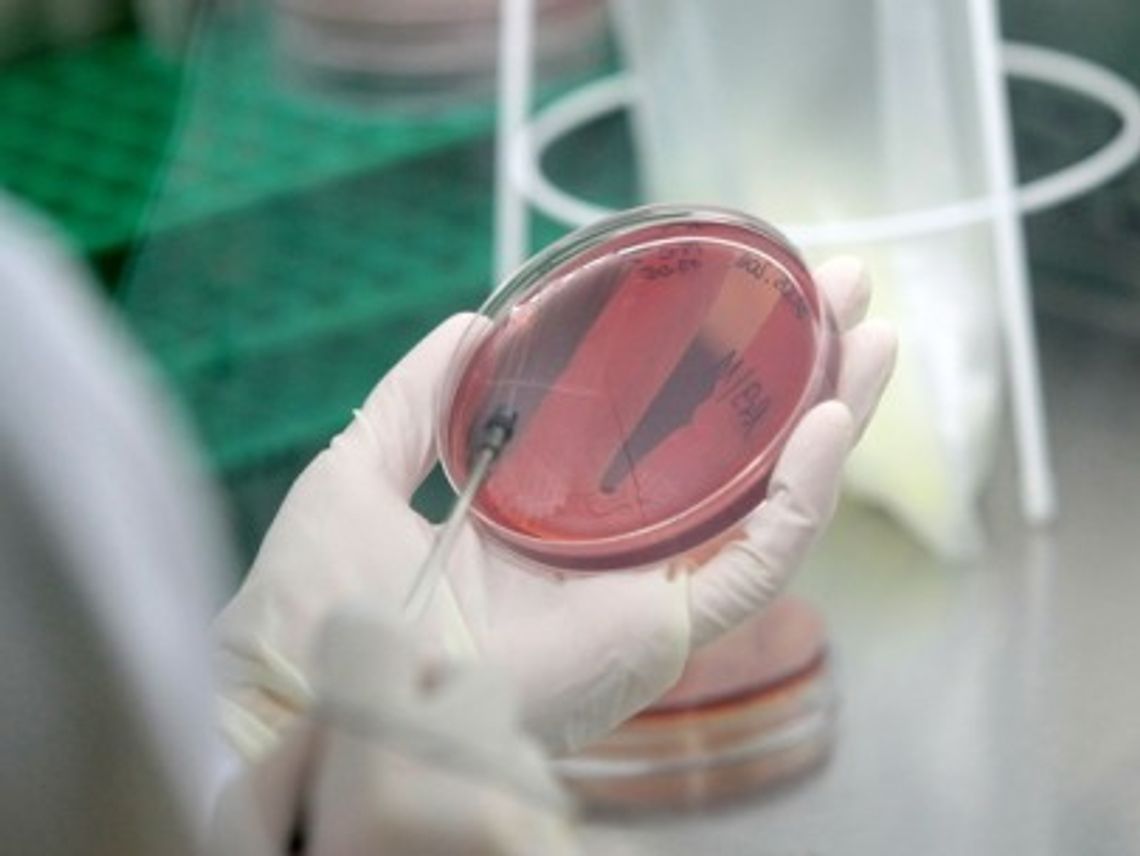
Bakterie grupy coli wykryto w wodzie Bakterie grupy coli wykryto w wodzie

Za jakość wody w Piasku odpowiada administrator ujęcia, tj. Wodociągi Zachodniopomorskie Sp. z o.o. w Goleniowie.
Reklama
Bakterie grupy coli wykryto w wodzie
Tylko po przegotowaniu mogą pić wodę mieszkańcy Piasku w gm. Cedynia. Taką decyzję wydał 15 lipca Państwowy Powiatowy Inspektor Sanitarny w Gryfinie. W próbce wody pochodzącej z sieci wodociągowej w miejscowości Piasek znaleziono bakterie grupy coli.
- 16.07.2015 05:36 (aktualizacja 01.08.2023 15:52)
Reklama
Reklama
Reklama







Napisz komentarz
Komentarze